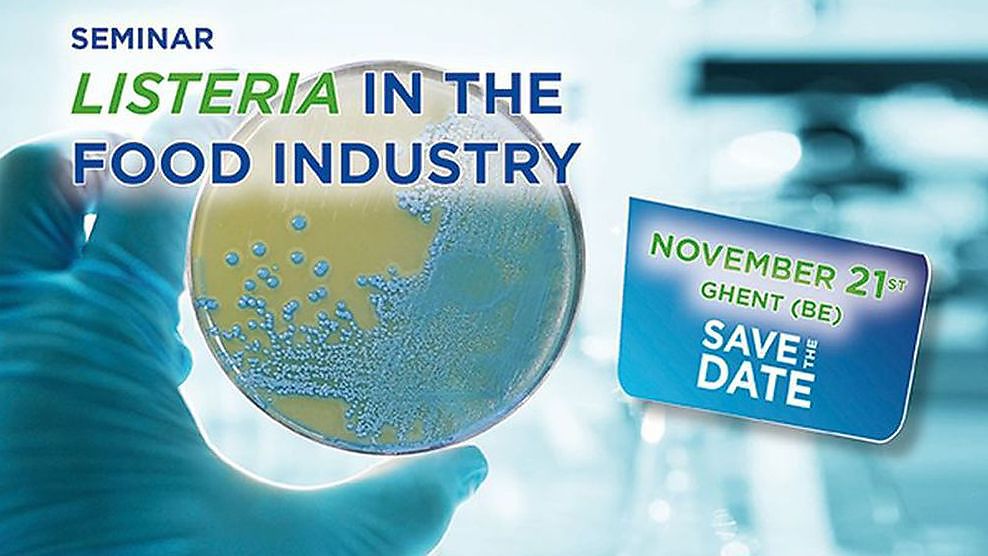

CHRISTEYNS
GENT
AFRIKALAAN 182
9000 GENT
9000 GENT
09/223.38.71
09.233.03.44
- ÉDUCATION
- NETTOYAGE
- CONTRÔLE DE LA CONTAMINATION
- TECHNOLOGIE DES PROCÉDÉS
- TRAITEMENT DE L’EAU
- SECURTITE & HYGIENE
- NETTOYAGE & HYGIÈNE
- LECTEURS GRAPHIC NEWS